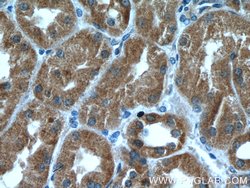

Promotional price valid on web orders only. Your contract pricing may differ. Interested in signing up for a dedicated account number?
Learn More
Learn More
ZC3HAV1 Mouse anti-Human, Clone: 1G10B9, Proteintech


Mouse Monoclonal Antibody
Supplier: Proteintech Group Inc 664131IG150UL

Description
The zinc finger antiviral protein (ZC3HAV1) is a CCCH type zinc finger protein that induces an innate immunity to infections by retrovirus by preventing the accumulation of viral RNAs in the cytoplasm and recruits the RNA processing exosome to degrade target RNAs, thereby inhibiting virus replication. ZC3HAV1 is localized in the cytoplasm at steady state, but shuttles between nucleus and cytoplasm in a XPO1-dependent manner. ZAP is a direct target gene of IRF3 action in cellular antiviral responses.Specifications
| ZC3HAV1 | |
| Monoclonal | |
| 1 mg/mL | |
| PBS with 50% glycerol and 0.02% sodium azide; pH 7.3 | |
| Q7Z2W4 | |
| ZC3HAV1 | |
| ZC3HAV1 Fusion Protein Ag10364 | |
| 150 μL | |
| Primary | |
| Human | |
| Antibody | |
| IgG1 |
| Immunocytochemistry, Immunofluorescence, Immunohistochemistry (Paraffin), Western Blot | |
| 1G10B9 | |
| Unconjugated | |
| ZC3HAV1 | |
| FLB6421, ZAP, ZC3H2, ZC3HAV1, ZC3HDC2, Zinc finger antiviral protein | |
| Mouse | |
| Protein G | |
| RUO | |
| 56829 | |
| -20°C | |
| Liquid |
Product Content Correction
The Fisher Scientific Encompass Program offers items which are not part of our distribution portfolio. These products typically do not have pictures or detailed descriptions. However, we are committed to improving your shopping experience. Please use the form below to provide feedback related to the content on this product.
Product Title
Spot an opportunity for improvement?Share a Content Correction